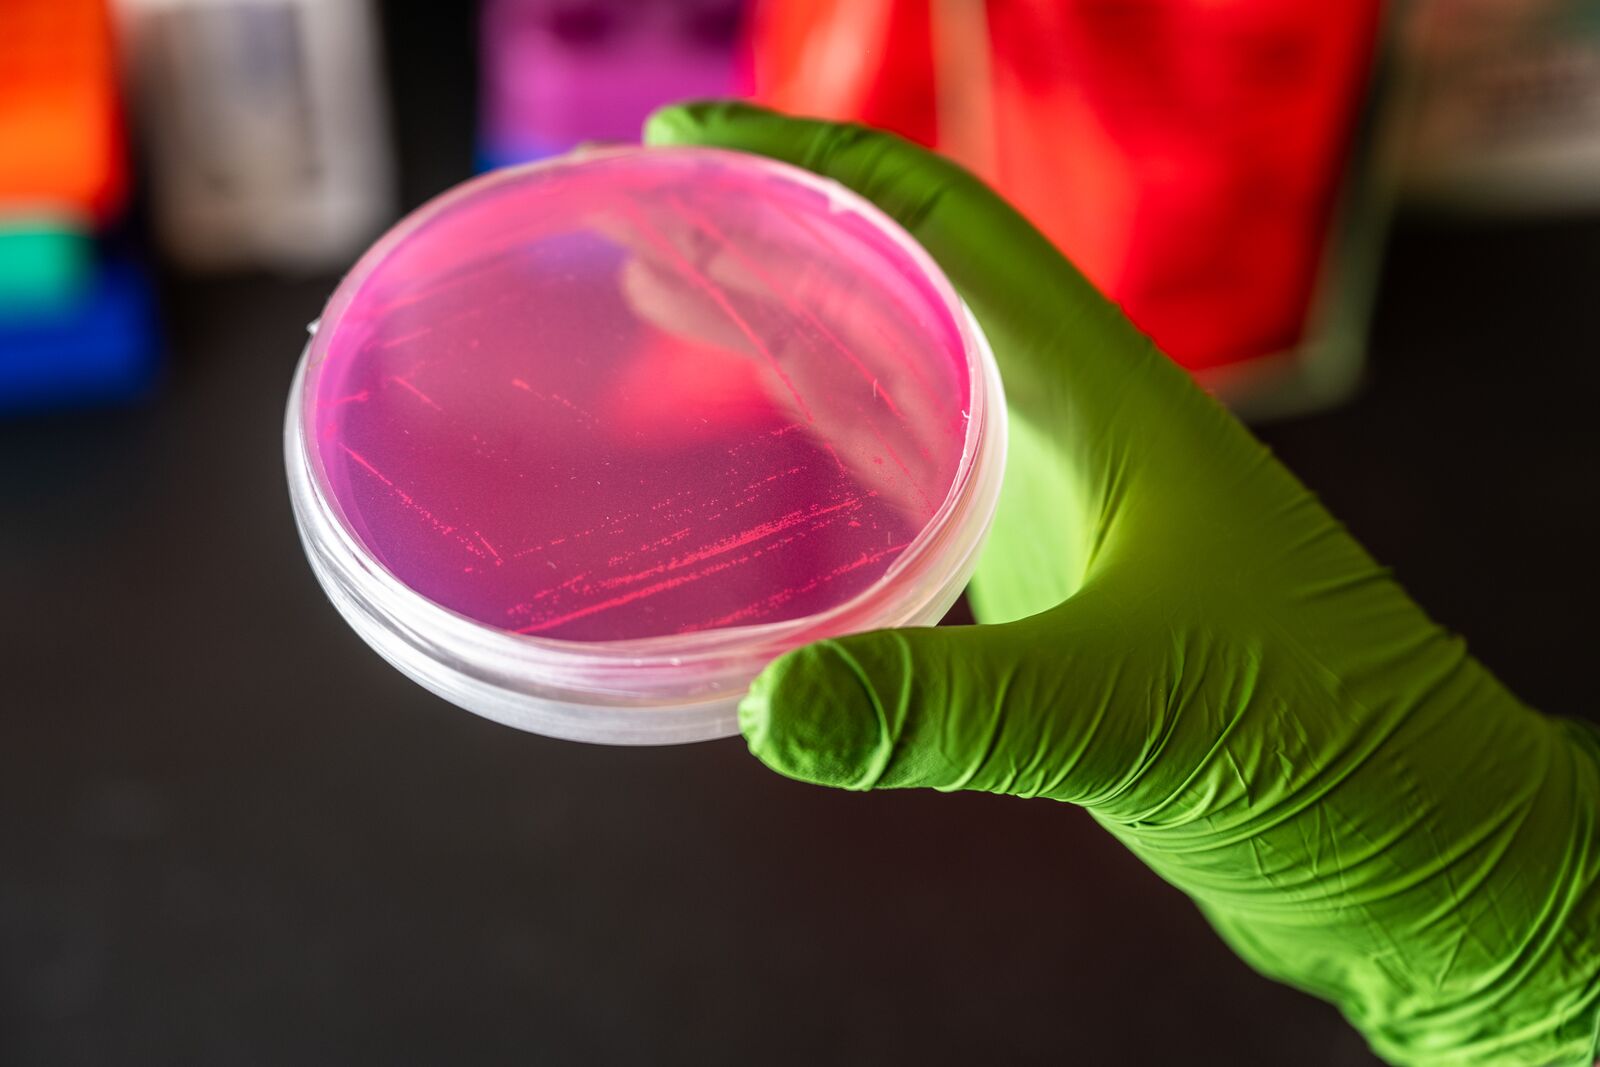

What is Phenomics?
Two bakers set out to create a cake with the same recipe and ingredients: Flour, sugar, eggs, baking soda, chocolate, and more. But the outcomes are strikingly different. One cake falls flat, burned to the core, while the other stands tall, fluffy and light and with a creamy middle. What gives?
The difference is in the steps the bakers took once they had the ingredients in hand. What was the temperature of the oven? In what order were the ingredients mixed? At what altitude were they cooking? And so on. Environmental factors are key.
The same is true for every living thing—people, animals, microbes.
We all have DNA—our starting instructions. That DNA codes for a collection of genes known as the genome.
We know a heap about genomes, and that knowledge is bearing fruit. One payoff has been better targeting drugs to those patients who benefit the most.
But scientists are confronting an uncomfortable fact: Life is about more than DNA.
The world beyond DNA is incredibly complex. The code of life is the essential starting point—but what that code calls for, the “instruction manual” it creates, is altered every moment of our lives, in ways that today are largely a mystery.
How is it that a leaf turns itself toward the sun to soak up as much sunshine as possible? How can some siblings look so alike and others look so different?
How does the environment influence the outcome?
How is life’s instruction manual modified and implemented by the world around us?
Answering that question is what phenomics is all about.
The word “phenome” describes the set of observable characteristics of an organism—tall or short, fast or slow and so on. DNA is the starting point, but then a riot of biochemical processes occur that bring about the actual traits of an organism.
Too much sunshine? Our body reacts by turning on genes that protect our skin from damaging ultraviolet light. A tree starved of water during a drought? The tree might react by activating genes that help it conserve water.
But how does this happen? What is the molecular basis of function?
To ask those questions is to venture into the world of phenomics, where hundreds or thousands of molecular actors like proteins change moment to moment in all living organisms—to try to understand the changes and how they result in the world we see and experience.
The challenge is great. The rewards could be huge.
Beyond the Genome: Predictive Phenomics
Understanding the steps between “what’s coded” (DNA) and “what is” (the phenome) would allow scientists to design and modify biological systems with unprecedented precision.
At Pacific Northwest National Laboratory, much of the study of phenomics focuses on microbes like bacteria, viruses, and fungi. The tiny organisms hold tremendous potential to play a role in remedies for climate change, developing sustainable materials, and creating bio-based fuels and chemicals as well as high-tech sensors for human health and national security.
In one experiment, scientists are learning how different microbes collaborate to store carbon underground. It turns out that different types of bacteria working together can store much more carbon in the soil than they can alone. They thrive through teamwork.
Scientists know this through phenomics by understanding how the environment shapes the biochemical activity of an organism. Recognizing the environmental conditions the bacteria need to survive and thrive—what temperatures, pH, concentrations, and with which microbial neighbors—could allow for the storage of vast amounts of carbon, an important tool to address increased carbon emissions.
The planned, intentional creation of a microbial community proficient at storing carbon is one example of predictive phenomics. A starting point is knowing who’s in the community and their genetic and biochemical make-up. Then researchers go further, identifying the environmental factors that affect that community, ultimately tweaking the signals to create a community to carry out the desired action—in this example, the efficient storage of carbon underfoot.
For biologists, life is much more than WYSIWYG—what you see is what you get. It’s about how we got there—understanding the processes involved to help shape what could be.
Phenomenal Phenomics
Phenomenal Phenomics
Predictive phenomics is a scientific superpower.
By understanding phenotypes—and being able to predict them—
we can do phenomenal things.
Predictive phenomics is a scientific superpower.
By understanding phenotypes—and being able to predict them—
we can do phenomenal things.